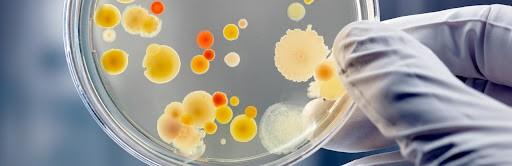

Autoras
G151006_24

Microbiología Epidemiologia de la enfermedad

 Elena Rodriguez Calderón
Francia Elena Silva Berrio
Albis Genith Hincapié Salas
Elena Rodriguez Calderón
Francia Elena Silva Berrio
Albis Genith Hincapié Salas
Afectación renal por Leishmaniasis en paciente con infecciónporelVIHyelVHBnoconocida.
https://www.revistanefrologia.com/index.php?p=revista&tipo=pdf-simple&pii=X18889700200 06660

• Identificación de todos los microorganismos y su relación clínica asociada al caso del artículo.
• De los microorganismos identificados, registre la triada epidemiológica de los que considere son los más relevantes en el caso clínico en estudio.
• Del caso clínico mencione los estudios realizados al paciente para el diagnóstico y explique los que considere que son relevantes en este caso.
• Del caso clínico mencione los tratamientos realizados al paciente y explique los que considere que son relevantes en el Estudio
• Desarrollo del caso con datos epidemiológicos a nivel nacional con los microorganismos del caso que considere más relevantes.
SHOP NOW
Identificacióndetodoslosmicroorganismosysu relaciónclínicaasociadaalcasodelartículo.
1. Leishmaniasis donovani.
2. VIH (virus de la inmunodeficiencia humana).
3. VHB (virus de la hepatitis B).
4. Citomegalovirus (CMV).
5. Herpes virus tipo 1.
6. Staphylococcus áureas.
7. VHC( Virus de la Hepatitis C).


De los microorganismos identificados, registre la triada epidemiológica de los que considere son losmásrelevantesenelcasoclínicoenestudio.
Leishmania donovani
https://www.canva.com/design/DAGEbKciX5k/ebNOPAdXQJ2w5pxh 7KtQRw/edit?utm_content=DAGEbKciX5k&utm_campaign=designs hare&utm_medium=link2&utm_source=sharebutton


VIH (virus de la inmunodeficiencia humana).
https://www.canva.com/design/DAGEbKciX5k/ebNOPAdXQJ2w5 pxh7KtQRw/edit?utm_content=DAGEbKciX5k&utm_campaign=d esignshare&utm_medium=link2&utm_source=sharebutton


VHB (virus de la hepatitis B).
https://www.canva.com/design/DAGEbKciX5k/ebNOPAdXQJ2w5 pxh7KtQRw/edit?utm_content=DAGEbKciX5k&utm_campaign=d esignshare&utm_medium=link2&utm_source=sharebutton


Citomegalovirus (CMV).
https://www.canva.com/design/DAGEbKciX5k/ebNOPAdXQJ 2w5pxh7KtQRw/edit?utm_content=DAGEbKciX5k&utm_cam paign=designshare&utm_medium=link2&utm_source=share button


Herpes virus tipo 1.
https://www.canva.com/design/DAGEbKciX5k/ebNOPAdXQJ 2w5pxh7KtQRw/edit?utm_content=DAGEbKciX5k&utm_cam paign=designshare&utm_medium=link2&utm_source=share button

Del caso clínico mencione los estudios realizados al paciente para el diagnóstico y explique los que considere que son relevantes en este caso.
Se hace estudios en laboratorio de la prueba de aglutinación en látex.
Ensayo inmuno enzimáticos (ELISA)
Biopsia y cultivo del bazo.
Cultivo y biopsia de médula ósea.
Prueba indirecta de anticuerpos inmuno fluorescentes.
Prueba de PCR específica para Leishmaniasis.
Cultivo y biopsia del hígado.


Prueba de serología para VIH y VHB con resultado positivo con problemas renales se sugiere biopsia renal
Analítica:
Hemoglobina, Volumen corpuscular medio, Reticulocitos, plaquetas, leucocitos, neutrófilos, sodio, potasio, cloro, lipasa, aspartato-transaminasa, alanina-transaminasa, g-glutamiltransferasa, fosfatasa ácida, bilirrubina total,; bilirrubina directa, proteínas totales, lactato-deshidrogenasa,
Radiografía de tórax , hilios engrosados con adenopatías calcificadas.
Prueba de Malaria sin hallazgos positivos
PRUEBAS COMPLEMENTARIAS
Tomografía viendo que tiene disminución de la captación renal bilateral compatible con insuficiencia renal, infección e inflamación de glándulas.
Ecocardiograma resultado hipertrofia concéntrica grave del ventrículo izquierdo
se diagnostica de glomerulonefritis membrana proliferativa tipo 1 secundaria a LV esta es causada por una respuesta inmunitaria anormal provocando inflamación en los filtros de los riñones y afectándolos por la cantidad de residuos de la sangre expulsándolos por la orina.




Del caso clínico mencione los tratamientos realizados al paciente y explique los que considere que son relevantes en el estudio..
Se inicia tratamiento antirretroviral con mejoría
El tratamiento para tratar la leishmaniasis
• Antimoniato de meglumina
• Estibo gluconato de sodio.
Otros medicamentos son
• Anfotericina B
• Ketoconazol
• Miltefosina
• Paromomicina
• Pentamidina

• Los farmacos que se usan para la afeccion renal le producen mas problemas en los riñones produciendo nefrotoxicidad.
• Tratamiento con anfotericina B liposoma mejorar el éxito clínico con mejoría progresiva en pacientes con VIH haciendo menos daño renal tratamiento por menos de un año y luego empezando medicamentos con antirretrovirales. Pero se suspende al mes por daños renales.
• Tratamiento con creatinina, pero a la semana empeora produciendo nefrotoxicidad.Asi que reducen dosis.
• Tratamiento con al menos 2 fármacos antihipertensivos
• Tratamiento antirretroviral (TAR) este ayuda en suprimir la replicación del VIH. Por 28 días todos los días
• Tratamiento con miltefosina Alopurinol: se administra de manera oral cada 12 horas durante 6-12 meses.

Complemente el desarrollo del caso con datos epidemiológicos a nivel nacional con los microorganismos del caso que considere más relevantes.

La leishmaniasis es una patología que se caracteriza por diversas especies y subespecies de protozoos, Identificados como Leishmaniasis.
Existen 20 especies identificadas que pueden afectar al ser humano y de ellas, 10 se encuentran en el ámbito colombiano. Se transmite mediante la picadura de insectos juveniles del género.
Lutzomyia (que requiere la presencia de madres para completar su etapa reproductiva
Existen 20 especies identificadas que pueden infectar al ser humano y de estas, 10 están presentes en territorio colombiano.


En Colombia, 16 especies son responsables delainfección, además delhombre.Lagran variedad de mamíferos domésticos y silvestres pueden ser refugio del parásito; los perros son fundamentales para el control y la vigilancia en el ámbito de la salud pública.
En el ámbito clínico se encuentran tres formasdelaenfermedad:cutánea,queesla másfrecuentetantoenColombiacomoenel mundo (comprendiendoentredel 98al 99 % de los casos), caracterizada por lesiones cutáneas de evolución prolongada, que se caracteriza por migración del parásito por vía hematógena o linfática a las mucosas nasal,oral,genital,entreotrasyvisceral.
A nivel mundial, se estima que hay cerca de 12 millones de personas infectadas (sin que esto implique desarrollo de manifestaciones clínicas), 350 millones de personas en riesgo de infectarse, 0,7 a 1,5 millones de casos nuevos al año y de 20 000 a 30 000 defunciones relacionadas con leishmaniasis visceral (1,2). En Colombia, con corte a SE 24 de 2022, se han notificado 2 156 casos de leishmaniasis cutánea, 30 casos de leishmaniasis mucosa y 4 confirmados de leishmaniasisvisceral(conunfallecimiento).






VHB
Las hepatitis de origen viral han incrementado gradualmente en Colombia pasando de una incidencia conjunta de 6,19 casos en el año 2016 a 9,65 en el 2018, donde el departamento de Norte de Santander presenta la mayor incidencia con 47,13 por 100.000 habitantes. La hepatitis A en Colombia registró un aumento del 57,7% en la incidencia, pasando de 2,6 (n= 1201) en el año 2015 a 4,1 (n=1957) por 100.000 habitantes en el año 2018; según la distribución por departamentos. Norte de Santander genera un fuerte aumento de la incidencia pasando de 3.3 por 100000 habitantes en e 2015 a 38 5 por 100000 habitantes en el año 2018 (Mapa1).
Según el informe del evento del Instituto Nacional de Salud, la incidencia de la Hepatitis A para el año 2019 fue de 7,5 por 100.000 habitantes, presentando comportamientos inusuales en el Departamento de Norte de Santander en los municipios de Cúcuta y Villa del Rosario (3). Para el tercer periodo epidemiológico del año 2020, se presentaron 489 casos, lo correspondiente a una tasa de 4,02 por 100.000 habitantes, evidenciando una disminución del 128,4% con respecto al año 2019 (1).
Existen 20 especies identificadas que pueden infectar al ser humano y de estas, 10 están presentes en territorio colombiano.



VIH

El virus de la inmunodeficiencia humana (VIH), que aún es uno de los principales problemas para la salud pública mundial, ha ocasionado 40,1 [33,6 a 48,6] millones de vidas. Su propagación se mantiene en todos los países, y en algunos de ellos las nuevas infecciones están disminuyendo, cuando antes se encontrabanenundescenso.
• Se evalúa que a finales de 2021 había 38,4 [33,9 a 43,8] millones de personasconcapacidaddetrabajo. Se han registrado más de dos tercios de ellas (25,6 millones) en la Región deÁfricadelaOMS
• Alo largo de ese año, fallecieron 650 000 [510 000-860 000] personas debido a las causas relacionadas con el virus. Un total de 1,5 (1,1- 2,0) millones contrajeron el virus.
La enfermedad no tiene cura, pero debido al acceso constante a la prevención, diagnóstico, tratamiento y atención eficaces en la prevención, el diagnóstico, la terapia y la atención eficaces del VIH y de las infecciones oportunistas.
se ha convertido en un estado de remordimiento constante. ¿Los pacientes pueden tener una vida digna?
Respirable y agradable.


• La OMS, el Fondo Mundial y la ONUSIDAse encuentran en posición de lucha contra el VIH, que se relacionan con el objetivo 3.3 de los Objetivos de Desarrollo.
Sostenible, consistente en poner fin a la epidemia de VIH en el futuro próximo.
• Para alcanzarlo, el 95% de las personas con VIH deben ser diagnosticadas, el 95% de ellas deben ingerir un tratamiento antirretrovírico (TAR) que protejan su vida, y el 95% de los casos tratados deben tener suprimida la carga vírica, tanto para salvaguardar su salud como para disminuir la transmisión del VIH.

